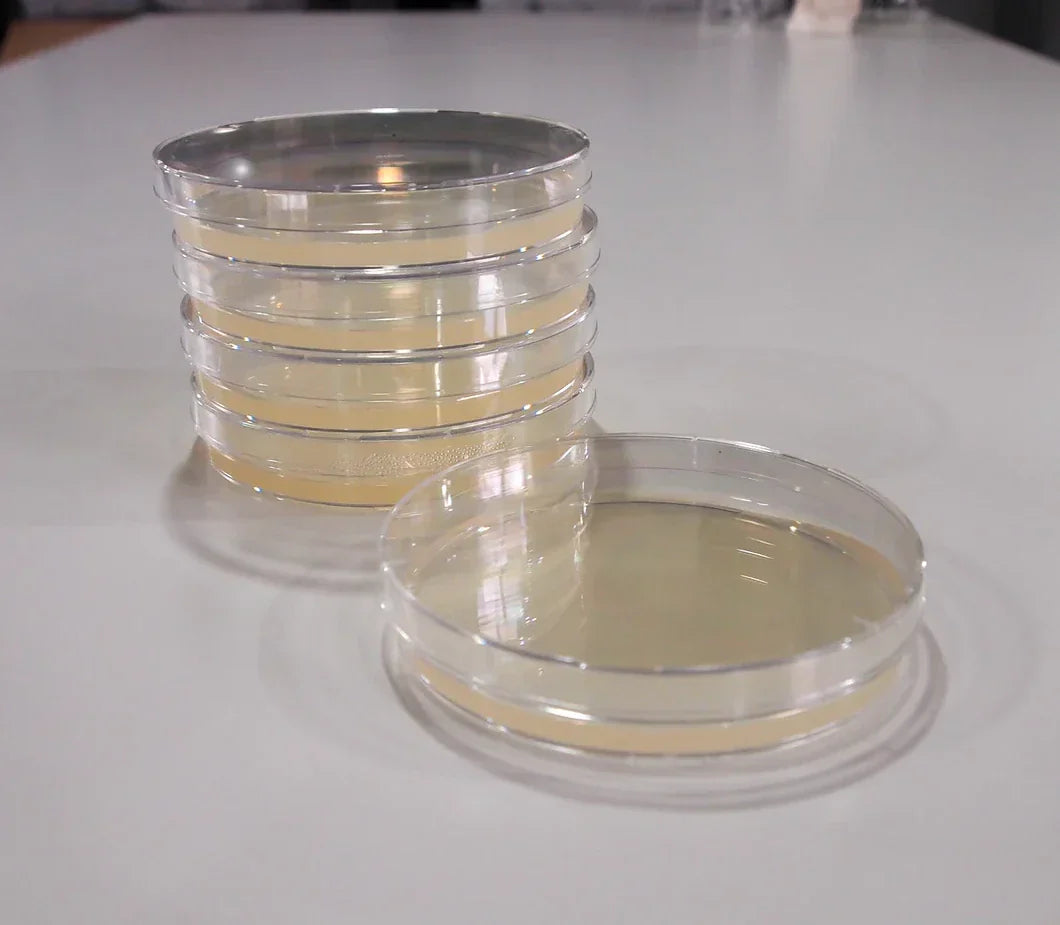

Share
All about agar - Using agar to grow your best mushrooms.
Which Agar Recipe Should You Choose?
When I first ventured into using agar, I was eager to discover the ideal recipe for my specific needs. Unfortunately, my initial search didn’t yield much helpful advice. Many recommendations boiled down to picking a random recipe, giving it a try, and experimenting until something worked. But selecting an agar recipe isn’t as simple as picking a favorite ice cream flavor—each recipe serves a unique purpose. To make the process easier, I’ve detailed four popular agar recipes below, along with explanations to help you determine which one is best suited to your goals.
Water Agar
This recipe contains no nutrients at all. It provides only water, which makes it highly resistant to contamination. Without nutrients, contaminants cannot grow. However, this also means that mycelium cannot feed and grow either, so water agar isn’t suitable for starting spores or liquid cultures.
Instead, water agar is used to isolate clean mycelium from an existing sample that is strong and healthy but may be contaminated. For example, if you’re working with a cutting from a wild-foraged mushroom, you can place the cutting on water agar. The healthy mycelium will use its stored energy to grow and spread out in search of food. This growth allows you to isolate a clean sample of mycelium, which can then be transferred to a more nutritious agar, such as malt extract agar, without carrying over any contaminants.
Malt Extract Agar (MEA)
Malt extract agar is a great choice for starting spores or tissue samples. It’s mildly nutritious, which supports mycelium growth. However, this also means that contaminants, if present, will grow as well. Fortunately, because MEA is only mildly nutritious, contaminants will grow more slowly and less vigorously. This gives you time to transfer healthy tissue away from contaminated areas.
While MEA supports mycelium growth, don’t expect the large, fluffy mycelial networks you might see in online photos. Its limited nutrients result in slower, more moderate growth—perfect for early-stage work but not for explosive growth.
Malt Yeast Agar (MYA)
This is the most nutritious of the three recipes; the next recipe is identical to this but with peptone added. It’s best used when you’re confident you have a clean sample of mycelium. On MYA, clean mycelium will grow thick, healthy, and strong. The increased nutrients encourage vigorous growth, which makes it ideal for promoting healthy mycelium.
However, if your sample is contaminated or becomes contaminated during transfer, the contaminants will also grow quickly and take over the plate. MYA is not forgiving of contamination, so it’s essential to ensure cleanliness when using this recipe.
Malt Yeast Peptone Agar (MYPA)
This is the previous MYA recipe supplemented with soya peptone. Adding peptone to agar provides several benefits for growing mushroom mycelium, as it serves as a rich source of nitrogen and amino acids, which are essential for mycelial growth. Here’s a breakdown of the key advantages:
-
Enhanced Nutritional Profile
Peptone is derived from proteins that are partially hydrolyzed into peptides and amino acids. These nutrients support the growth and metabolic activity of mycelium, especially for species that thrive on nitrogen-rich media. -
Promotes Faster Colonization
The additional nutrients from peptone can stimulate faster mycelial colonization on the agar, which is particularly useful when working with slow-growing species or when you need quick results. -
Supports Robust Mycelial Growth
Peptone helps produce thicker, more vigorous mycelial networks, which can improve the transfer success to other media, such as grain or substrate. -
Aids in Recovering Weak Cultures
For cultures that have been weakened or are recovering from contamination, peptone-enriched agar can provide the extra nutrients necessary to boost their vitality and encourage regrowth. -
Encourages Secondary Metabolite Production
The addition of peptone may also stimulate the production of secondary metabolites, which could enhance the overall health of the culture or improve its resistance to contaminants.
Considerations When Using Peptone:
-
Concentration: Adding too much peptone can make the medium overly rich, potentially favoring bacterial contamination. A typical concentration is around 0.1–0.5% of the total medium.
-
Compatibility: It works best with general-purpose agar recipes and may not be necessary for all mycelial species, so tailor its use to the needs of the specific mushroom strain.
By enriching your agar with peptone, you can create an optimal environment for robust and healthy mycelial growth, making it a valuable addition to your toolkit for mushroom cultivation.
Now the Recipes:
Water Agar:
This recipe makes 500ml of Water Agar.
(Approximately 25-30, 100mm petri dishes)
Ingredients:
-
Water - 500ml
-
Agar - 10 grams
Malt Extract Agar (MEA):
This recipe makes 500ml of Malt Extract Agar (MEA)
(Approximately 25-30, 100mm petri dishes)
Ingredients:
-
Agar - 10 grams
-
Malt Extract - 7.5 grams
Malt Yeast Agar (MYA):
This recipe makes 500ml of Malt Yeast Agar (MYA)
(Approximately 25-30, 100mm petri dishes)
IMPORTANT: Nutritional Yeast is typically sold in flake form. The flakes will need to be ground into a fine powder prior to mixing into your recipe. A simple mortar and pestle or coffee grinder will do the trick.
Ingredients:
-
Water - 500ml
-
Agar - 10 grams
-
Malt Extract - 7.5 grams
-
Nutritional Yeast Powder - 0.25 grams
Malt Yeast Peptone Agar (MYPA):
This recipe makes 500ml of Malt Yeast Peptone Agar (MYPA)
(Approximately 25-30, 100mm petri dishes)
IMPORTANT: Nutritional Yeast is typically sold in flake form. The flakes will need to be ground into a fine powder prior to mixing into your recipe. A simple mortar and pestle or coffee grinder will do the trick.
Ingredients:
-
Water - 500ml
-
Agar - 10 grams
-
Malt Extract - 7.5 grams
-
Nutritional Yeast Powder - 0.25 grams
-
Soya Peptone - 0.25 gram
Preparing the Agar:
The first step in preparing agar is ensuring you have all the supplies you will need ready at hand. In addition to the ingredients for each recipe, you will need some additional items:
-
Petri dishes (or for a cheaper option, consider disposable condiment cups)
-
A pot or bowl in which to mix the ingredients
-
A bottle or jar to autoclave or sterilize the agar using a pressure cooker
-
A pressure cooker
-
A flow hood or still-air box in which to pour your agar plates
-
Parafilm or zip-top baggies to protect the agar plate from contaminants
Disposable plastic condiment cups are available in the plastic cup/plate aisle in your grocery store, or buy in bulk online.
Instructions:
-
Heat water to boiling and remove from heat.
-
Combine water with dry ingredients and mix well.
-
You can optionally add small amounts of your substrate or spawn grain (ground into a powder) into the mix to lessen "jumping off" time.